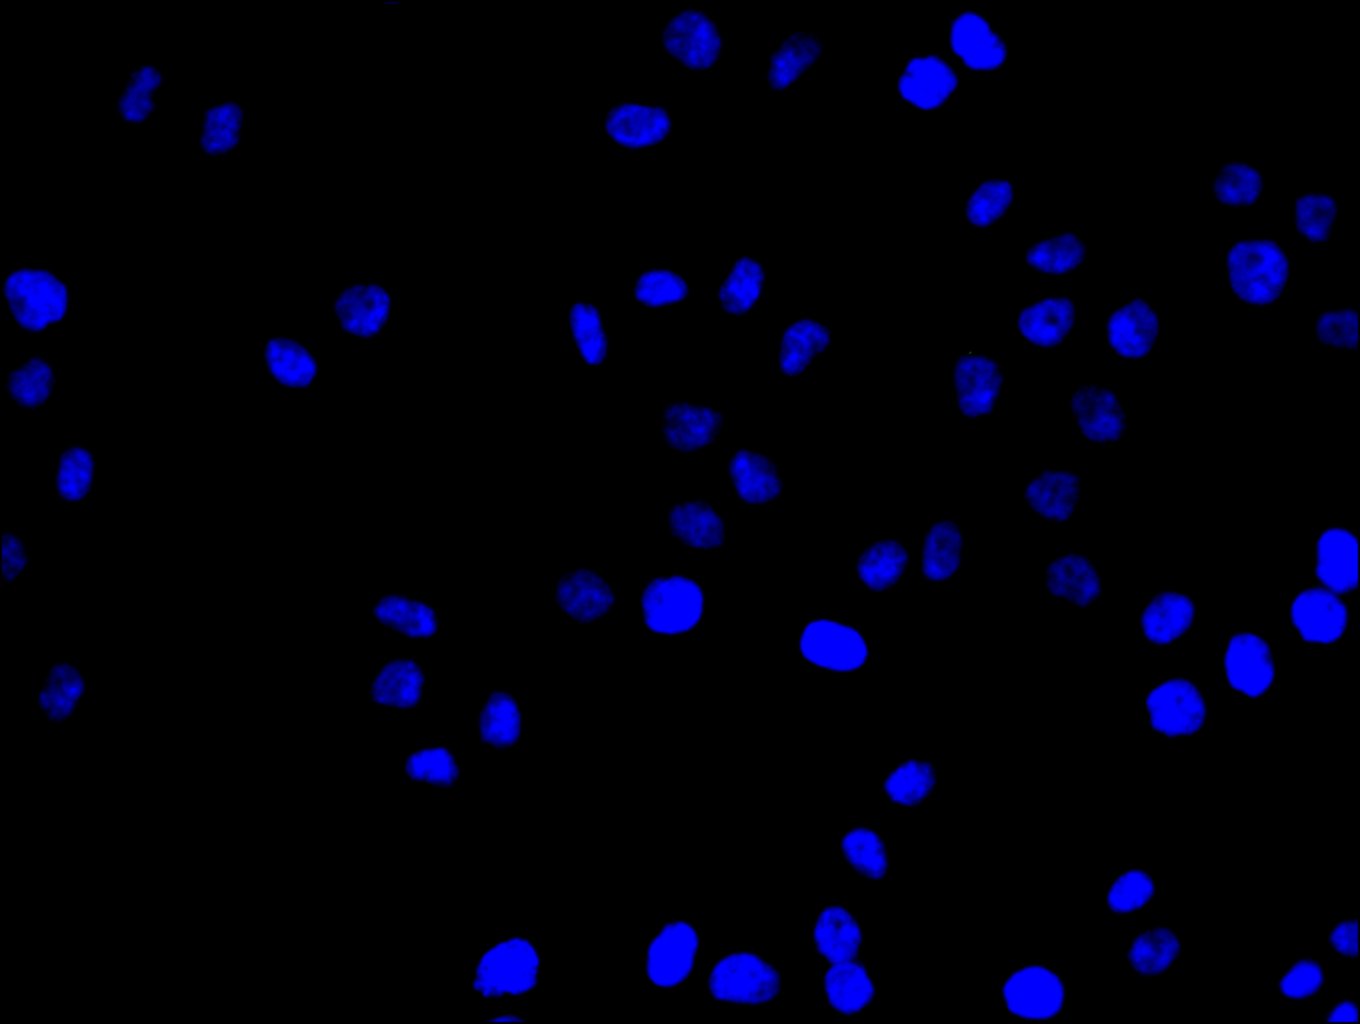

CDC25C Recombinant Monoclonal Antibody
-
中文名稱:CDC25C重組抗體
-
貨號:CSB-RA004996A0HU
-
規格:¥1320
-
圖片:
-
Western Blot
Positive WB detected in: K562 whole cell lysate(30μg)
All lanes: CDC25C antibody at 1:1000
Secondary
Goat polyclonal to rabbit IgG at 1/20000 dilution
Predicted band size: 54 kDa
Observed band size: 60 kDa
Exposure time: 120s -
IHC image of CSB-RA004996A0HU diluted at 1:80 and staining in paraffin-embedded human testis tissue performed on a Leica BondTM system. After dewaxing and hydration, antigen retrieval was mediated by high pressure in a citrate buffer (pH 6.0). Section was blocked with 10% normal goat serum 30min at RT. Then primary antibody (1% BSA) was incubated at 4°C overnight. The primary is detected by a Goat anti-rabbit polymer IgG labeled by HRP and visualized using 0.05% DAB. Secondary antibody only control: uses 1% BSA instead of primary antibody
-
Immunofluorescence staining of Hela cell with CSB-RA004996A0HU at 1:50, counter-stained with DAPI. The cells were fixed in 4% formaldehyde and and permeated by 0.2% TritonX-100 for 15 min. Then 10% normal goat serum to block non-specific protein-protein interactions . The cells were then incubated with the antibody overnight at 4℃. The secondary antibody was Alexa Fluor 488-congugated AffiniPure Goat Anti-Rabbit IgG(H+L).
-
Immunofluorescence staining of Hela cell with 5% goat serum, counter-stained with DAPI. The cells were fixed in 4% formaldehyde and blocked in 10% normal Goat Serum. The cells were then incubated with the antibody overnight at 4C. The secondary antibody was Alexa Fluor 488-congugated AffiniPure Goat Anti-Rabbit IgG(H+L).
-
Immunofluorescence staining of U251 cell with CSB-RA004996A0HU at 1:50, counter-stained with DAPI. The cells were fixed in 4% formaldehyde and and permeated by 0.2% TritonX-100 for 15 min. Then 10% normal goat serum to block non-specific protein-protein interactions . The cells were then incubated with the antibody overnight at 4℃. The secondary antibody was Alexa Fluor 488-congugated AffiniPure Goat Anti-Rabbit IgG(H+L).
-
Immunofluorescence staining of U251 cell with 5% goat serum, counter-stained with DAPI. The cells were fixed in 4% formaldehyde and blocked in 10% normal Goat Serum. The cells were then incubated with the antibody overnight at 4C. The secondary antibody was Alexa Fluor 488-congugated AffiniPure Goat Anti-Rabbit IgG(H+L).
-
-
其他:
產品詳情
-
產品描述:CSB-RA004996A0HU CDC25C重組單克隆抗體是針對細胞周期調控關鍵因子CDC25C開發的高特異性試劑。該磷酸酶通過調控CDK1活性參與G2/M期轉換及DNA損傷應答,在腫瘤發生發展過程中發揮重要作用。本抗體經多種平臺嚴格驗證:在免疫印跡實驗中能特異性識別內源性蛋白,免疫組化分析可清晰定位細胞核內表達,免疫熒光技術成功應用于亞細胞定位研究,免疫共沉淀實驗證實其高效捕獲靶蛋白能力,同時滿足ELISA檢測的靈敏性需求。其寬泛的稀釋范圍(WB 1:500-5,000;IHC 1:50-200;IF 1:20-200;IP 1:200-1,000)適用于不同實驗體系的蛋白檢測需求,特別適合細胞周期調控機制研究、腫瘤相關信號通路解析及DNA損傷修復模型構建。重組單克隆技術確保抗體批次間高度一致性,為細胞增殖研究、轉化醫學實驗及分子互作網絡分析提供可靠工具,尤其適合需要長期穩定性的科研項目。
-
Uniprot No.:
-
基因名:
-
別名:CDC 25 antibody; Cdc 25C antibody; CDC25 antibody; CDC25C antibody; Cell division cycle 25 homolog C antibody; Cell division cycle 25C antibody; Cell division cycle 25C protein antibody; Dual specificity phosphatase Cdc25C antibody; M phase inducer phosphatase 3 antibody; M-phase inducer phosphatase 3 antibody; Mitosis inducer CDC25 antibody; MPIP3 antibody; MPIP3_HUMAN antibody; Phosphotyrosine phosphatase antibody; PPP1R60 antibody; protein phosphatase 1, regulatory subunit 60 antibody
-
反應種屬:Human
-
免疫原:A synthesized peptide derived from human CDC25C
-
免疫原種屬:Homo sapiens (Human)
-
標記方式:Non-conjugated
-
克隆類型:Monoclonal
-
抗體亞型:Rabbit IgG
-
純化方式:Affinity-chromatography
-
克隆號:3E6
-
濃度:It differs from different batches. Please contact us to confirm it.
-
保存緩沖液:Rabbit IgG in 10mM phosphate buffered saline , pH 7.4, 150mM sodium chloride, 0.05% BSA, 0.02% sodium azide and 50% glycerol.
-
產品提供形式:Liquid
-
應用范圍:ELISA, WB, IHC, IF
-
推薦稀釋比:
Application Recommended Dilution WB 1:500-1:2000 IHC 1:50-1:200 IF 1:50-1:200 -
Protocols:
-
儲存條件:Upon receipt, store at -20°C or -80°C. Avoid repeated freeze.
-
貨期:Basically, we can dispatch the products out in 1-3 working days after receiving your orders. Delivery time maybe differs from different purchasing way or location, please kindly consult your local distributors for specific delivery time.
-
用途:For Research Use Only. Not for use in diagnostic or therapeutic procedures.
相關產品
靶點詳情
-
功能:Functions as a dosage-dependent inducer in mitotic control. Tyrosine protein phosphatase required for progression of the cell cycle. When phosphorylated, highly effective in activating G2 cells into prophase. Directly dephosphorylates CDK1 and activates its kinase activity.
-
基因功能參考文獻:
- Cells lacking ARID1A show enhanced AURKA transcription, which leads to the persistent activation of CDC25C, a key protein for G2/M transition and mitotic entry. PMID: 30097580
- FHL1 increase inhibitory CDC25 phosphorylation by forming a complex with CHK2 and CDC25, and sequester CDC25 in the cytoplasm by forming another complex with 14-3-3 and CDC25, resulting in increased radioresistance in cancer cells. PMID: 28094252
- CDC25A plays a novel role in regulating the malignant behavior of glioma stem cells as a part of Linc00152/miR-103a-3p/FEZF1/CDC25A axis. PMID: 28651608
- Overexpression of the CDK1 and CDC25A may have a role in the pathogenesis of the NFPA. PMID: 28004354
- Mdm2 overexpression and Cdc25C downregulation delay cell cycle progression through the G2/M phase. PMID: 28806397
- Xanthatin functions as a DNA-damaging agent in non-small cell lung carcinomas by activating Chk1-mediated DDR and lysosome-mediated degradation of Cdc25C. PMID: 29074359
- Myelodysplastic syndrome -related P95 point mutants of SRSF2 lead to alternative splicing of CDC25C in a manner that is not dependent on the DNA damage response. PMID: 27552991
- The aim of this review is to shed light on the role of four different phosphatases (PTEN, PP2A, CDC25 and DUSP1) in five different solid tumors (breast cancer, lung cancer, pancreatic cancer, prostate cancer and ovarian cancer), in order to better understand the most frequent and aggressive primary cancer of the central nervous system, glioblastoma. PMID: 28801478
- Data show that TRIB2-mediated degradation of CDC25C is associated with lysine-48-linked CDC25C polyubiquitination driven by the TRIB2 kinase-like domain. PMID: 27563873
- High expression of pCHK2-Thr68 was associated with decreased patient survival (p = 0.001), but was not an independent prognostic factor. Our results suggest that pCHK2-Thr68 and pCDC25C-Ser216 play important roles in breast cancer and may be potential treatment targets PMID: 27801830
- the biology of the activation/deactivation of CDC25 by kinases/phosphatases to maintain the level of CDK-cyclin activities and thus the genomic stability PMID: 27038604
- the knockdown of CDC25C can reduce both the radiotherapy sensitivity and the proliferation activity of EC9706 cells. PMID: 27188256
- results identify CDC25C as a downstream target of the mutated tyrosine kinase FLT3-ITD affecting cell-cycle regulation in a model of AML PMID: 27919943
- Suggest that the p53-p21-DREAM-CDE/CHR pathway regulates p53-dependent repression of Survivin, CDC25C, and PLK1 in HCT116 cells. PMID: 26595675
- These miR-142-3p functioned as a tumor suppressor by targeting CDC25C. PMID: 26805039
- Cdc25C negatively regulates proapoptotic ASK1 in a cell cycle-dependent manner and may play a role in G2/M checkpoint-mediated apoptosis. PMID: 25633196
- Recurrent CDC25C mutations drive malignant transformation in familial platelet disorder to acute myelogenous leukaemia. PMID: 25159113
- we conclude that inhibition of KIF22 suppresses cancer cell proliferation by delaying mitotic exit through the transcriptional upregulation of CDC25C. PMID: 24626146
- These findings indicate that DHM inhibits the growth of hepatocellular carcinoma (HCC) cells via G2/M phase cell cycle arrest through Chk1/Chk2/Cdc25C pathway PMID: 24002546
- Purification and biochemical analysis of catalytically active human cdc25C dual specificity phosphatase PMID: 23567337
- protein plays a role in regulating PCa cell growth, and androgen treatments, but not EGF, greatly increase Cdc25C protein levels in AS PCa cells, which is in part by decreasing its degradation. PMID: 23637932
- dose-dependent Cdc25c phosphatase acts as an early G2-phase checkpoint, thus indicating mechanistic importance in the low-dose hyper-radiosensitivity and induced radioresistance transition PMID: 22843362
- data suggest that the maintenance of CDC25 activity does not fully rely on the thioredoxin reductase system in breast cancer cells, even in the presence of a major oxidative stress PMID: 22360685
- cloning and functional analysis of Cdc25C PMID: 22394631
- MMEQ induced G2/M arrest through the promotion of cdc25c in TSGH8301 cells. PMID: 22021033
- Inhibition of CK2 activity by three different inhibitors led to a down-regulation of the level of cdc25C. PMID: 21750987
- Two additional sites other than Ser216 in the widely studied cell division cycle (Cdc) protein 25C, whose function depends on 14-3-3 binding, were identified. PMID: 21189416
- The results show for the first time that in human mitosis, distinct phospho-isoforms of cdc25C exist with different localizations and interacting partners. PMID: 20668692
- ATM and Chk1/2 mediated phosphorylation of cdc25c plays a major role in cell cycle arrest induced by pectenotoxin2. PMID: 20514472
- CDC25C and phospho-CDC25C (Ser216) play a crucial role in the pathogenesis and/or progression of vulvar squamous cell carcinomas. PMID: 20500813
- Adventitious arsenate reductase activity of the catalytic domain of the human and Cdc25C phosphatases PMID: 20025242
- Analysis of cell cycle profile and cell cycle regulatory proteins indicated that arsenite arrested cell cycle at G(2)/M phase, partially through induction of cell division cycle 25 (Cdc25) isoform C (Cdc25C) degradation via ubiquitin-proteasome pathways PMID: 11842186
- results suggest that Plk1 phosphorylates Cdc25C on Ser198 and regulates nuclear translocation of Cdc25C during prophase PMID: 11897663
- role of degradation by oxidative stress in induction of cell cycle arrest PMID: 11925443
- Human CDC25B and CDC25C differ by their ability to restore a functional checkpoint response after gene replacement in fission yeast PMID: 12099692
- Ca2+ promotes erythrocyte band 3 tyrosine phosphorylation via dissociation of phosphotyrosine phosphatase from band 3. PMID: 12175337
- phosphorylation by Chk2 PMID: 12386164
- CDC25C is phosphorylated on Ser 214 during mitosis which, in turn, prevents phosphorylation of Ser 216. HeLa cells depeleted of endogenous CDC25C, when treated with exogenous CDC25C, had a substantial delay to mitotic entry. PMID: 12766774
- cdc25C not only plays a role at the G2/M transition but also in the modulation of DNA replication PMID: 12857880
- CDC25C translocation to the cell nucleus upon entry into mitosis is coordinated by Plk3 PMID: 14968113
- binding to VPR protein in human cell lines correlates with G2 arrest PMID: 14972559
- downregulation of Cdc25C is mediated by p53 via two independent mechanisms, one involving direct binding to the cdc25C promoter PMID: 15574328
- Vpr promotes cell cycle arrest at the G(2)/M phase by facilitating association of 14-3-3 and Cdc25C PMID: 15708996
- Vitamin C transiently arrests cancer cell cycle progression in S phase and G2/M boundary by modulating the kinetics of activation of CDC25C. PMID: 15887239
- Data suggests that CDC25C might play an important role in prostate cancer progression and could be used to monitor and predict the aggressiveness of this disease. PMID: 16000564
- Data suggest that Pim-1 activates Cdc25C by a direct phosphorylation and can thereby assume the function of a positive cell cycle regulator at the G2/M transition. PMID: 16356754
- Crystallization experiments of PLK1 protein in complex with an unphosphorylated and a phosphorylated target peptide from Cdc25C yield crystals suitable for X-ray diffraction analysis. PMID: 16582488
- These results demonstrate that the MAPK ERK signaling pathway contributes to the p53-independent antiproliferative functions of p14ARF. Furthermore, they identify a new mechanism by which phosphorylation at serine 216 participates to Cdc25C inactivation. PMID: 16582626
- Phosphorylation of cdc25c can be used to test whether a pharmacologic inhibitor of Plk1 would exert the same cellular effects as interference with Plk1 on an mRNA level. PMID: 16648550
- Chk1-mediated phosphorylation of Cdc25C plays a major role in response to LOR-mediated G(2)/M arrest. Although the Chk1-mediated cell growth arrest in a tumor cell line. PMID: 16649252
顯示更多
收起更多
-
亞細胞定位:Nucleus.
-
蛋白家族:MPI phosphatase family
-
數據庫鏈接:
Most popular with customers
-
-
YWHAB Recombinant Monoclonal Antibody
Applications: ELISA, WB, IHC, IF, FC
Species Reactivity: Human, Mouse, Rat
-
Phospho-YAP1 (S127) Recombinant Monoclonal Antibody
Applications: ELISA, WB, IHC
Species Reactivity: Human
-
-
-
-
-